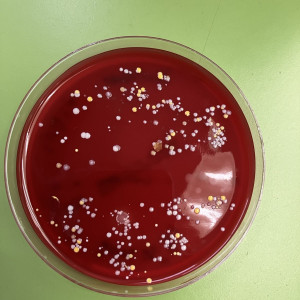
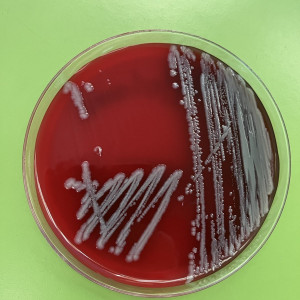

Bakterien & Co.
IPad, Türklinke, Mülltonne, Toilettenschüssel, Bauchnabel, Zehen, Papierspender oder der Auffang einer Kaffeekanne. Wenn man diese Begriffe hört, würde man bei der Frage „Wo kann man die meisten Bakterien finden?“ wahrscheinlich erst einmal an die Mülltonne oder die Türklinke denken. Was aber wenn wir euch sagen, was es in Wirklichkeit ist?
Eine Woche vor unserem Aufbruch ins UKSH-Labor bekamen wir im Biologie-Unterricht die Aufgabe, Abstriche aus dem ganzen Johanneum zu nehmen. Dabei kamen viele verschiedene Konstellationen zustande, wie zum Beispiel die oben genannten Gegenstände. Kurz danach mussten wir diese in Aga abstreichen, um sie eine Woche später mikroskopieren zu können.
Am darauffolgenden Dienstag gingen also die 10d und die Ea unter Leitung von Frau Jochims und Herrn Rolfes ins Labor. Eingepackt in Einweg-Kittel hörten wir uns erst eine kurze Anweisung an, wie wir uns im Labor zu verhalten hatten, bis wir schließlich vieles über Bakterien und deren Bedeutung gelernt haben. Nach einer Stunde ging es für uns dann ans Praktische, und wir präparierten unsere Proben. Unter dem Mikroskop konnten wir uns die genauere Struktur der Bakterien ansehen, die sich die Woche über gebildet hatten.
Nach einer kleinen Pause ging es dann an die Auswertung. Wir haben uns die verschiedenen Abstriche angeguckt und konnten dann auch schließlich sehen, an welchem Ort am Johanneum man die meisten Bakterien finden kann. Tatsächlich beim Kaffeetrinken…
Vielen Dank an alle die uns diesen Wandertag ermöglicht haben!
Pia Jannsen, 10d, für die Presse-AG
Fotos: Frau Jochims